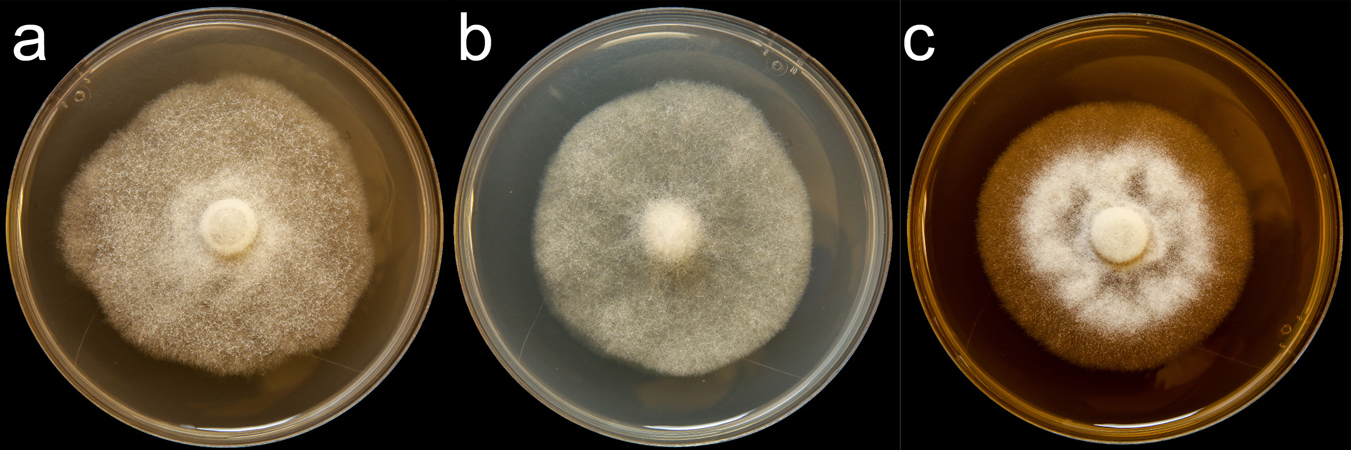

Phytophthora ×cambivora (in progress - Abad et al. 2023b)
|
Phytophthora spp. in subclade 7a: portion of the seven-loci ML phylogeny featuring the type cultures of 212 described species (by T. Bourret). Notice the position of P. ×cambivora Ex-type CBS 141218 = S&T BL 225. Gloria Abad, USDA S&T.
|
|
Phytophthora spp. in subclade 7a: Morphological Tabular key (PDF) and Tabular key legends (PDF) in IDphy2 KEY SECTION. Notice the data of P. ×cambivora Ex-type CBS 141218 = S&T BL 225. Gloria Abad, USDA S&T.
|
|
Phytophthora cambivora (CPHST BL 155) colonies of selected specimen #1 grown for 7 days on (a) V8® Agar, (b) potato dextrose agar, and (c) malt extract agar; photo by Krysta Jennings and Leandra Knight, USDA-APHIS-PPQ |
|
Phytophthora cambivora (CPHST BL 34G) colonies of a selected specimen grown for 7 days on (a) V8® Agar, (b) potato dextrose agar, and (c) malt extract agar; photo by Clinton Greub, Krysta Jennings, and Leandra Knight, USDA-APHIS-PPQ |
|
Phytophthora cambivora (Abad PH197) selected specimen sexual phase: (a-d) morphology of the oogonia, antheridia, and oospores after pairing with opposite type; photos by G. Abad, USDA-APHIS-PPQ |
|
basal lesion on Castanea sativa caused by Phytophthora cambivora in Sardinia, Italy; photo by Bruno Scanu and Antonio Franceschini, Università degli Studi di Sassari, Italy |
|
microphylly and yellowish foliage on Castanea sativa caused by Phytophthora cambivora in Italy; photo by Bruno Scanu and Antonio Franceschini, Università degli Studi di Sassari, Italy |
Name and publication
Phytophthora ×cambivora (Petri) Buisman (1927)
Buisman CJ. 1927. Root rots caused by Phycomycetes. Mededeelingen van het Phytopathologisch Laboratorium "Willie Commelin Schol- ten", Baarn, 11: 1–51. Diss. Utrecht: 1–51 (pg 4) Phytophthora cambivora.
Nomenclature
from Buisman (1927)
Mycobank
Synonymy
≡ Blepharospora cambivora Petri, Bot. Zh. SSSR (J. Bot. U.S.S.R.): 297 (1917) [MB146731]
Etymology
from the Latin "cambium" and “devouring”
Typification
Type: ITALY, Torino from Castanea sativa CBS 152.24 described as Blepharospora cambivora by Petri 1917
HerIMI: IMI 38995 authentic for the name of Blepharospora cambivora Petri 1928
Ex-type: CBS 152.24 (LOST)
Well-authenticated specimen(s) selected by Gloria Abad:
Selected specimen #1: CPHST BL 155 = P19997 (WPC)
Selected specimen #2: CPHST BL 34G = P0592 (WPC)
Selected specimen #1 in other collections
CPHST BL 155 (Abad) (A1) = P19997 (WPC)
CPHST BL 34G (Abad) (A2) = P0592 (WPC) = CBS 114087, ATCC 46719, P592 [20]
Ex-type in other collections
(ENT) CBS 141218, NRRL 64019, TJ0197, P711, S&T BL 225 (Abad), V/3+4B
Molecular identification
Voucher sequences for barcoding genes (ITS rDNA and COI) of the ex-type (see Molecular protocols page)
Phytophthora cambivora isolate CPHST BL 155 (= P19997 WPC) = ITS rDNA MG783387, COI MH136860
Phytophthora cambivora isolate CPHST BL 34G (= P0592 WPC) = ITS rDNA MG783388, COI MH136861
Additional sequences for molecular identification
Phytophthora cambivora isolate P0592: ITS rDNA HQ261516, COI HQ261263
Voucher sequences for Molecular Toolbox with seven genes (ITS, β-tub, COI, EF1α, HSP90, L10, and YPT1
(see Molecular protocols page) (In Progress)
Voucher sequences for Metabarcoding High-throughput Sequencing (HTS) Technologies [Molecular Operational Taxonomic Unit (MOTU)]
(see Molecular protocols page) (In Progress)
Sequences with multiple genes for ex-type in other sources
- NCBI: Phytophthora cambivora CPHST BL 155
- NCBI: Phytophthora cambivora P0592
- Phytophthora DATABASE: Phytophthora cambivora PD_00043 = P0592
- EPPO-Q-bank: Phytophthora cambivora
Position in multigenic phylogeny with 7 genes (ITS, β-tub, COI, EF1α, HSP90, L10, and YPT1)
Clade 7a
Genome sequence of selected specimen
Phytophthora cambivora CBS 114087 = CPHST BL 34G = P0592 WPC
Morphological identification
Colonies and cardinal temperatures
Colonies in V-8, PDA, and MEA with no distinctive pattern. Minimum temperature for growth is 2°C, optimum is 22–24°C, and maximum 32°C.
Asexual phase
Sporangia nonpapillate, persistentpersistent:
pertaining to sporangia that remain attached to the sporangiophore and do not separate or detach easily (cf. caducous)
, ovoidovoid:
egg-shaped, with the widest part at the base of the sporangium and the narrow part at the apex
, obpyriformobpyriform:
inversely pear-shaped, i.e. with the widest part at the point of attachment (cf. pyriform)
, or elipsoid (55–65 µm x 40–45 µm), showing internal and often nested proliferationnested proliferation:
a type of internal proliferation where a new sporangium develops successively inside the old sporangium after it has emptied
, oroginated on simple, unbranched sporangiophores. Hyphal swellings rarely produced and are coralloid with irregular shapes. ChlamydosporesChlamydospores:
an asexual spore with a thickened inner wall that is delimited from the mycelium by a septum; may be terminal or intercalary, and survives for long periods in soil
are absent.
Sexual phase
Heterothallic. OogoniaOogonia:
the female gametangium in which the oospore forms after fertilization by the antheridium
showing characteristic bullate wall projections, antheridiaantheridia:
the male gametangium; a multinucleate, swollen hyphal tip affixed firmly to the wall of the female gametangium (the oogonium)
amphygynous showing one or 2 cells when paired with the opposite mating typemating type:
molecular mechanisms that regulate compatibility in sexual reproduction in heterothallic species (also referred to as compatibility type); typically denoted as A1 or A2
. OosporesOospores:
zygote or thick-walled spore that forms within the oogonium after fertilization by the antheridium; may be long-lived
pleroticplerotic:
pertaining to an oospore that fills the oogonium (cf. aplerotic)
.
Most typical characters
Phytophthora cambivora is heterothallicheterothallic:
pertaining to sexual reproduction in which conjugation is possible only through interaction of different thalli (i.e. different mating types) (cf. homothallic)
, forming oogoniaoogonia:
the female gametangium in which the oospore forms after fertilization by the antheridium
with characteristic warty, or bullate walls, and 2-celled antheridiaantheridia:
the male gametangium; a multinucleate, swollen hyphal tip affixed firmly to the wall of the female gametangium (the oogonium)
.
Specimen(s) evaluated
Selected specimen #1: Phytophthora cambivora CPHST BL 155 (A1) (Abad) = P19997 [World Phytophthora Collection (WPC) California, USA]
Selected specimen #2: Phytophthora cambivora CPHST BL 34G (A2) (Abad) = P0592 [World Phytophthora Collection (WPC) California, USA]
Hosts and distribution
Distribution: cosmopolitan
Substrate: roots, stems, especially base of trunk
Disease note: canker, crown and root rot, often in conjunction with other Phytophthora spp.
Hosts: 30 genera in 19 families, including Castanea (chestnut, Fagaceae)
Retrieved January 29, 2018 from U.S. National Fungus Collections Nomenclature Database.
Additional references and links
- SMML USDA-ARS: Phytophthora ×cambivora
- EPPO Global Database: Phytophthora ×cambivora
- Forest Phytophthoras of the world: Phytophthora ×cambivora
- Wikipidia: Phytophthora ×cambivora
- Encyclopedia of Life (EOL): Phytophthora ×cambivora
- Index Fungorum (IF): Phytophthora ×cambivora
- Google All Phytophthora ×cambivora
- Google Images Phytophthora ×cambivora
- Google Scholar Phytophthora ×cambivora
Fact sheet author
Z. Gloria Abad, Ph.D., USDA-APHIS-PPQ-S&T Plant Pathogen Confirmatory Diagnostics Laboratory (PPCDL), United States of America.